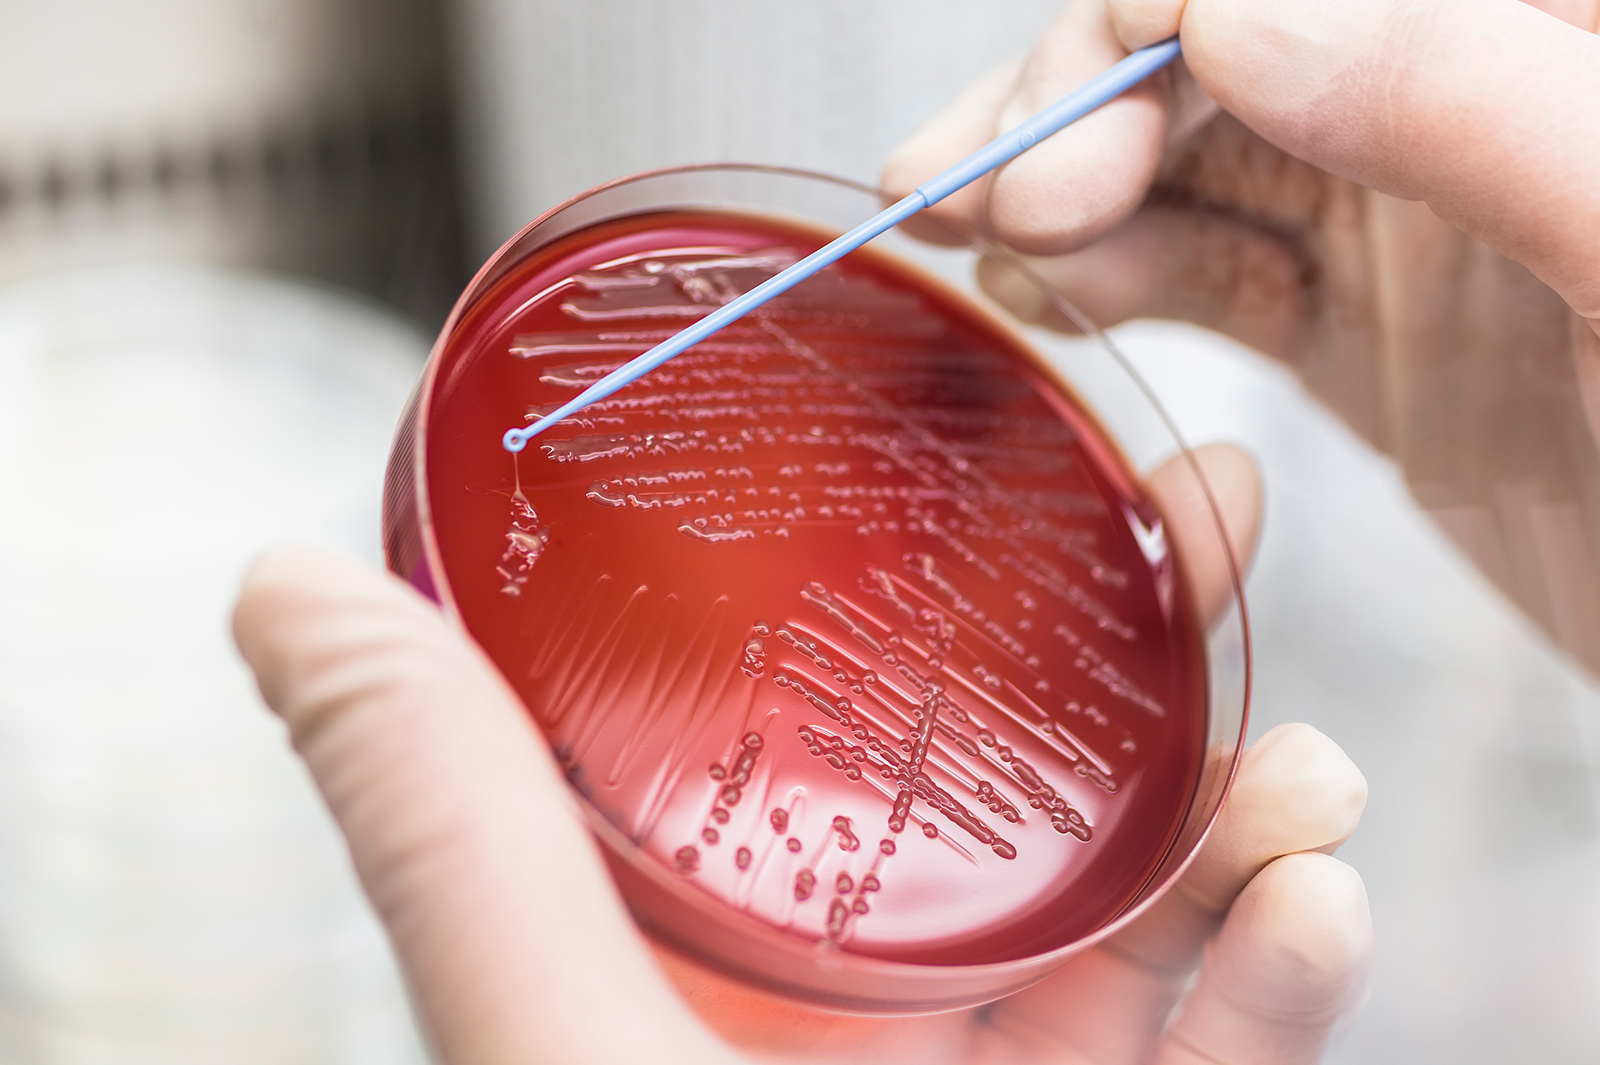
Prof Chen Sheng

CityU secures research funding from the RGC to tackle the global public health threat from hypervirulent, multidrug-resistant pathogens

A research project led by a scholar at City University of Hong Kong (CityU), titled "Multi-disciplinary approaches to tackling the global public health threat of hypervirulent and multidrug-resistant (MDR) Klebsiella pneumoniae" received HK$38 million in research funding in the 12th round of the Theme-based Research Scheme (TRS) under the Research Grants Council (RGC) of the University Grants Committee (UGC) for a five-year project.
Klebsiella pneumoniae is part of the normal gut flora and is the most common opportunistic pathogen, especially in elderly and immunosuppressed patients. The research team, led by Professor Chen Sheng, Associate Dean of CityU’s Jockey Club College of Veterinary Medicine and Life Sciences, and Professor in the Department of Infectious Diseases and Public Health, will adopt a multifaceted approach to prevent the possible occurrence of a pandemic of the hypervirulent, MDR Klebsiella pneumoniae, and develop novel therapies to treat infections caused by the pathogen to reduce the threat to human health and social development posed by this super-virulent strain.
The Klebsiella pneumoniae pathogen has consistently evolved over the past two decades, generating genetic variants of mixed phenotypes of antibiotic resistance and virulence. Infections caused by the newly evolved strains are hard to prevent, diagnose and treat. To date, Klebsiella pneumoniae has become the most frequently isolated bacterial pathogen in hospital settings, with a mortality rate of over 40% recorded worldwide.
Adopting a multidisciplinary collaborative approach, the CityU team will investigate the ongoing and future evolution trends of this important pathogen, depict the key genetic features of high-risk strains, and develop new molecular methods that will allow clinicians to rapidly distinguish between infections caused by high and low risk strains, and implement appropriate treatment and infection control strategies. New approaches will also be developed to treat infections caused by the high-risk Klebsiella pneumoniae strains by inhibiting the expression of virulence factors, drug-resistance enzymes, and novel antibacterial targets to be identified in the project.
Based on a large amount of experimental data, the CityU team predicts that there is a risk of a pandemic in the form of a significantly increased incidence of serious Klebsiella pneumoniae infections among not only hospital patients, but also healthy individuals, because these strains can invade and cause infections in various body sites. The infections are characterised by long hospital stays, infections in multiple organs and high mortality.
Professor Chen thanks CityU and the RGC for their strong support for this research project. He said that a pandemic of Klebsiella pneumoniae infections is imminent and that this research is particularly important for safeguarding human health. "The development of the new diagnostic and treatment techniques will effectively prevent the possible occurrence of a Klebsiella pneumoniae infections if the proposed research can be carried out promptly. The benefits associated with the successful avoidance of a Klebsiella pneumoniae pandemic in society and the world economy are immeasurable, including enormous savings in healthcare costs and safeguarding productivity and economic activities that would be lost in a pandemic,” he said.
The Theme-based Research Scheme (TRS) under the RGC aims to focus academic research efforts of UGC-funded universities on themes of strategic importance to the long-term development of Hong Kong. There are four designated research themes under the TRS: (1) Promoting Good Health; (2) Developing a Sustainable Environment; (3) Enhancing Hong Kong's Strategic Position as a Regional and International Business Centre; and (4) Advancing Emerging Research and Innovations Important to Hong Kong. Under the four research themes are 19 grand challenge topics. The proposals are assessed on academic excellence based on their qualification standards, their potential impact on Hong Kong, the credentials of the project team, the team’s strategy, and the structure of the research project.